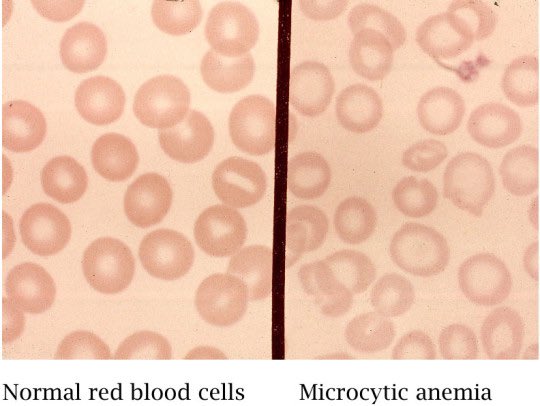

✨ في هذا الثريد راح اتكلم عن التحاليل والاختبارات التي تُستخدم للكشف عن فقر الدم، أيضاً المعدلات الطبيعية لكل واحد 👍🏻
ولا ننسى أمثلة عن بعض الحالات المرضية المصاحبة لها في حال الارتفاع أو الانخفاض عن المستوى الطبيعي 👌🏻
ولا ننسى أمثلة عن بعض الحالات المرضية المصاحبة لها في حال الارتفاع أو الانخفاض عن المستوى الطبيعي 👌🏻
🔻 الـ CBC - تحليل صورة دم كاملة
1️⃣ خلايا الدم الحمراء أو RBCs - مسؤولة عن نقل الاوكسجين 👍🏻
🌀 المعدل الطبيعي:
للـ Female —> 4.2 - 5.4 million cells/mcL
للـ Male —> 4.7 - 6.1 million cells/mcL
1️⃣ خلايا الدم الحمراء أو RBCs - مسؤولة عن نقل الاوكسجين 👍🏻
🌀 المعدل الطبيعي:
للـ Female —> 4.2 - 5.4 million cells/mcL
للـ Male —> 4.7 - 6.1 million cells/mcL
⚠️ ترتفع في حالات، مثل:
⁃ Polycythemia Vera
⁃ Heart failure
⚠️ تنخفض في حالات، مثل:
⁃ Anemia
⁃ Bone Marrow failure
⁃ Polycythemia Vera
⁃ Heart failure
⚠️ تنخفض في حالات، مثل:
⁃ Anemia
⁃ Bone Marrow failure
2️⃣ خلايا الدم البيضاء أو WBCs - تدخل في الجهاز المناعي ومسؤولة عن محاربة العدوى 👍🏻
🌀 المعدل الطبيعي:
4K - 11K cells/mm3
⚠️ ترتفع في حالات، مثل:
⁃ Infection
⁃ Inflammation
⁃ Leukemia (ALL-AML-CLL-CML)
⚠️ تنخفض في حالات، مثل:
⁃ Aplastic Anemia
⁃ Leukemia
🌀 المعدل الطبيعي:
4K - 11K cells/mm3
⚠️ ترتفع في حالات، مثل:
⁃ Infection
⁃ Inflammation
⁃ Leukemia (ALL-AML-CLL-CML)
⚠️ تنخفض في حالات، مثل:
⁃ Aplastic Anemia
⁃ Leukemia
3️⃣ الـ Hct - Hematocrit فكرته راح يقيس كم عدد خلايا الدم الحمراء بالدم كله، يُقاس بالنسبة بالمئوية %
🌀 المعدل الطبيعي:
للـ Female —> 36% - 48%
للـ Male —> 41% - 50%
⚠️ ترتفع في حالات، مثل:
⁃ Dehydration
⁃ Polycythemia Vera
⚠️ تنخفض في حالات، مثل:
⁃Anemia
🌀 المعدل الطبيعي:
للـ Female —> 36% - 48%
للـ Male —> 41% - 50%
⚠️ ترتفع في حالات، مثل:
⁃ Dehydration
⁃ Polycythemia Vera
⚠️ تنخفض في حالات، مثل:
⁃Anemia
4️⃣ MCV - Mean corpuscular Volume يقيس حجم خلية الدم الحمراء، ويُعتبر من الاشياء المهمه خلال الشخيص، يقاس بالـ "Femtoliter "fl
🌀 المعدل الطبيعي:
80 fl 100 - fl
🌀 المعدل الطبيعي:
80 fl 100 - fl
〽️ اذا كان الـ MCV في المعدل الطبيعي 80fl - 100fl —> Normocytic
الخلية تحت المجهر بتطلع بالحجم الطبيعي ولكن
ممكن يكون لدى المريض أنيما ولكن نوع آخر👌🏻
الخلية تحت المجهر بتطلع بالحجم الطبيعي ولكن
ممكن يكون لدى المريض أنيما ولكن نوع آخر👌🏻
5️⃣ MCH - Mean corpuscular Hemoglobin يقيس متوسط كمية الـ Hb في خلية دم حمراء 👌🏻، يُقاس بالـ "Picogram "pg
🌀المعدل الطبيعي:
27.5 - 33.2 pg
⚠️ترتفع في حالات، مثل:
⁃ Macrocytic Anemia
⁃ B12 - folic Acid Deficiency
⚠️ تنخفض في حالات، مثل:
⁃ Lack of Iron
🌀المعدل الطبيعي:
27.5 - 33.2 pg
⚠️ترتفع في حالات، مثل:
⁃ Macrocytic Anemia
⁃ B12 - folic Acid Deficiency
⚠️ تنخفض في حالات، مثل:
⁃ Lack of Iron
6️⃣ MCHC - Mean Corpuscular Hemoglobin Concentration يقيس متوسط تركيز الـ Hb في خلية دم حمراء واحدة 👌🏻 ، يُقاس بالـ g/dL
🌀 المعدل الطبيعي:
33.4 - 35.5 g/dL
⚠️ترتفع في حالات، مثل:
⁃ Hemolytic Anemia
⁃ Sickle Cell Anemia
⚠️ تنخفض في حالات، مثل:
⁃ Iron Deficiency
🌀 المعدل الطبيعي:
33.4 - 35.5 g/dL
⚠️ترتفع في حالات، مثل:
⁃ Hemolytic Anemia
⁃ Sickle Cell Anemia
⚠️ تنخفض في حالات، مثل:
⁃ Iron Deficiency
7️⃣ RDW - Red Cell Distribution Width يقيس المسافة بين خلايا الدم الحمراء، ف إذا كان في أحجام مختلفة لخلايا الدم الحمراء —> راح يتاثر بالقياس ويرتفع 👌🏻، يُقاس بالنسبة المئوية %
🌀 المعدل الطبيعي:
للـ Female —> 12 - 16%
للـ Male —> 11.8 - 14.5%
🌀 المعدل الطبيعي:
للـ Female —> 12 - 16%
للـ Male —> 11.8 - 14.5%
⚠️ترتفع في حالات، مثل:
⁃ Iron - B13 - Folic Acid Deficiency
⁃ Iron - B13 - Folic Acid Deficiency
🔻 الـ Reticulocyte Count
الـ Retic عبارة عن Immature RBC، تحت المجهر راح تظهر وسط الخلية بـ Fragment of nuclear material وهو عبارة عن RNA
🌀 المعدل الطبيعي:
أقل من 2%
الـ Retic عبارة عن Immature RBC، تحت المجهر راح تظهر وسط الخلية بـ Fragment of nuclear material وهو عبارة عن RNA
🌀 المعدل الطبيعي:
أقل من 2%
⚠️ ترتفع في حالات، مثل:
⁃ Hemolytic Anemia
⚠️ تنخفض في حالات، مثل:
⁃Irons Deficiency Anemia
⁃Aplastic Anemia
⁃ Hemolytic Anemia
⚠️ تنخفض في حالات، مثل:
⁃Irons Deficiency Anemia
⁃Aplastic Anemia
Loading suggestions...